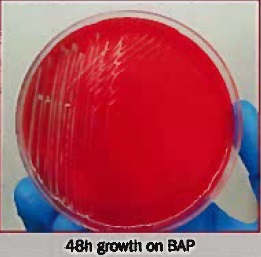

A 65 year old, patient 1, who did not have a travel history outside the United States, presented at the ED for hematuria, left upper quadrant pain, generalized weakness, and a fever of 100°F. He was admitted for suspected viral illness causing idiopathic thrombocytopenia and acute cholecystitis. However, CT scan and RUQ ultrasound upon admission was negative for cholecysitits. His AST and ALT were elevated. Blood parasite smears were ordered to rule out Babesia, which were negative. HIV and Ehrlichia antibodies were also negative. Blood cultures (BC) were also drawn on hospital day (HD) 1.
His BC became positive 3 days after incubation, with the initial Gram stain showing tiny gram negative coccobacilli (Figure 1). FilmArray Blood culture Identification panel-2 (BCID-2) returned negative. BC broth was sub-cultured to Blood, chocolate, and MacConkey agar plates and a haze of growth was observed on the BAP (Figure 2) and Choc plates after 48 hours of incubation. No growth on MAC. Our laboratory could not rule out Brucella or Burkholderia after a battery of biochemical tests (oxidase: strong positive, catalase positive, no satellite growth, nitrite positive) performed in BSL3. The isolate was then referred to the state department of health (DOH), which provided a final identification of Brucella suis. The history revealed that he ate raw beef and sushi a week before his symptoms appeared.
One week after patient 1 admission, a 50 year old male (patient 2) presented to ED with 2 weeks of unexplained fever, chills, headache and occasional vomiting. Blood cultures were drawn prior to admission. Malaria screening was also performed due to his recent travel history of South Eastern Africa. Patient 3, a 36 year old female also presented with similar symptoms 2 days after patient 2 was admitted. However, Patient 3 had a recent travel to Eastern Africa. Her blood cultures were also drawn. In both patients, HIV Ag/Ab screening, malaria, Babesia, Erhlichia PCR, and Quantiferon were negative. Liver panels were also performed on both patient 2 and 3. Both ALT and AST were elevated, which is a common theme in all three patients. Both patients 2 and 3 drank unpasteurized camel milk during their trips. Similar to patient 1, the blood cultures of patient 2 and 3 became positive three days after incubation. Since the growth pattern and Gram stain characteristics of blood bottle subcultures was similar to that of patient 1, the isolates were sent to the DOH as soon as a haze of growth appeared on the media. Both isolates were identified as Brucella melitensis.
Discussion
Brucella spp. are facultative, small gram negative coccobacilli and tend to appear as clusters on the Gram stain. Brucella melitensis is the most common cause of human infection followed by B. suis and B. abortus although the latter two can be more prevalent in certain geographical regions. B. canis infection in human is rare. Brucellosis is a zoonotic disease. Most industrialized countries, with effective public health measures, have managed to control the infection. According to 2019 report by CDC, 165 cases of Brucellosis were reported in the United States. Brucella infections in certain parts of the world are particularly associated with drinking raw unpasteurized goat or camel milk.
Brucellosis symptoms appear between 1-4 weeks after exposure. Clinical presentations of Brucellosis are often nonspecific and can mimic malaria or typhoid fever in those returning from the endemic areas; therefore, Brucellosis is considered “the disease of mistakes.” One of the organ systems commonly affected in Brucellosis is liver, with the manifestation of acute liver failure and unexplained thrombocytopenia. Approximately 25 to 35 percent of Brucellosis patients have high AST and ALT associated with low platelet levels. A similar profile was observed in our patients presented here.
While person-to-person transmission is rare, Brucella is the most common laboratory acquired infection (LAI). LAI occurs via aerosolization of Brucellae upon manipulation of isolates on open benches. Manipulation includes picking colonies for rapid biochemical tests, MALDI-ToF, or susceptibility testing on an open bench. Notable LAI’s due to Brucella are reported by New York State Department of Health in 2015-2017, when more than 200 cases of laboratory workers were exposed. Because the infectious dose for Brucella is extremely low (5CFU/mL), it is considered a highly pathogenic category B Bioterrorism agent. LAI can be prevented if clinicians notify the clinical laboratory of suspicious Brucella cases when samples are sent for cultures.
Most laboratories today utilize rapid molecular blood culture panels for initial identification of positive blood cultures. Microbiology laboratories should implement a bio-alert “rule out or refer” protocol to minimize exposure when 1) rapid molecular blood culture identification multiplex panels fail to detect any organisms; 2) prolonged incubation time (blood culture bottles and subculture media) in most cases; 3) atypical Gram stain characteristics (small coccobacilli that typically tend to cluster in positive blood cultures and sometimes appear as gram variable); and 4) growth only on blood and chocolate, but not on MacConkey agar.
Identification of Brucella by MALDI-ToF or any commercial methods in sentinel laboratories is highly prohibited. Biochemical tests must be performed in a biosafety cabinet to rule out potential biothreat agents. In most cases, MALDI-ToF systems can misidentify select bioagents. One salient example was a case report by the Yale University Clinical Microbiology Laboratory, where Brucella was misidentified as Ochrobactrum anthropi by Vitek MS.
Because of a diverse range of clinical symptoms, definitive diagnosis of Brucellosis is mainly achieved by laboratory findings by means of serology or isolation of organisms in culture. Serologic diagnosis requires two serum samples – the first sample taken during the acute phase of illness and the latter should be taken 2-4 weeks. A rise in antibodies of four fold or higher is considered positive Brucellosis. The Laboratory Reference Network and Center for Disease Control (CDC) can perform Brucella microagglutination test (BMAT) for B. melitensis, B. suis, and B. abortus. American Society of Microbiology (ASM), Association of Public Health Laboratories (APHL), and Laboratory Response Network (LRN) have diagnostic protocols and guidelines for ruling out or refer potential Brucella from culture isolation.

References
- Kazak E, Akalın H, Yılmaz E, Heper Y, Mıstık R, Sınırtaş M, Özakın C, Göral G, Helvacı S. Brucellosis: a retrospective evaluation of 164 cases. Singapore Med J. 2016 Nov;57(11):624-629. doi: 10.11622/smedj.2015163. Epub 2015 Nov 13. PMID: 26768063; PMCID: PMC5331138.
- Ackelsberg J, Liddicoat A, Burke T, Szymczak WA, Levi MH, Ostrowsky B, Hamula C, Patel G, Kopetz V, Saverimuttu J, Sordillo EM, D’Souza D, Mitchell EA, Lowe W, Khare R, Tang YW, Bianchi AL, Egan C, Perry MJ, Hughes S, Rakeman JL, Adams E, Kharod GA, Tiller R, Saile E, Lee S, Gonzalez E, Hoppe B, Leviton IM, Hacker S, Ni KF, Orsini RL, Jhaveri S, Mazariegos I, Dingle T, Koll B, Stoddard RA, Galloway R, Hoffmaster A, Fine A, Lee E, Dentinger C, Harrison E, Layton M. BrucellaExposure Risk Events in 10 Clinical Laboratories, New York City, USA, 2015 to 2017. J Clin Microbiol. 2020 Jan 28;58(2):e01096-19. doi: 10.1128/JCM.01096-19. PMID: 31694974; PMCID: PMC6989065.
- Manual of Clinical Microbiology. 11th edition. 2018.
- Poonawala H, Marrs Conner T, Peaper DR. The Brief Case: Misidentification of Brucella melitensis as Ochrobactrum anthropi by Matrix-Assisted Laser Desorption Ionization-Time of Flight Mass Spectrometry (MALDI-TOF MS). J Clin Microbiol. 2018 May 25;56(6):e00914-17. doi: 10.1128/JCM.00914-17. PMID: 29802238; PMCID: PMC5971538.
- https://www.cdc.gov/brucellosis/exposure/areas.html

-Phyu M. Thwe, Ph.D., D(ABMM), MLS(ASCP)CM is Microbiology Technical Director at Allina Health Laboratory in Minneapolis, MN. She completed her CPEP microbiology fellowship at the University of Texas Medical Branch in Galveston, TX. Her interest includes appropriate test utilization and extra-pulmonary tuberculosis.